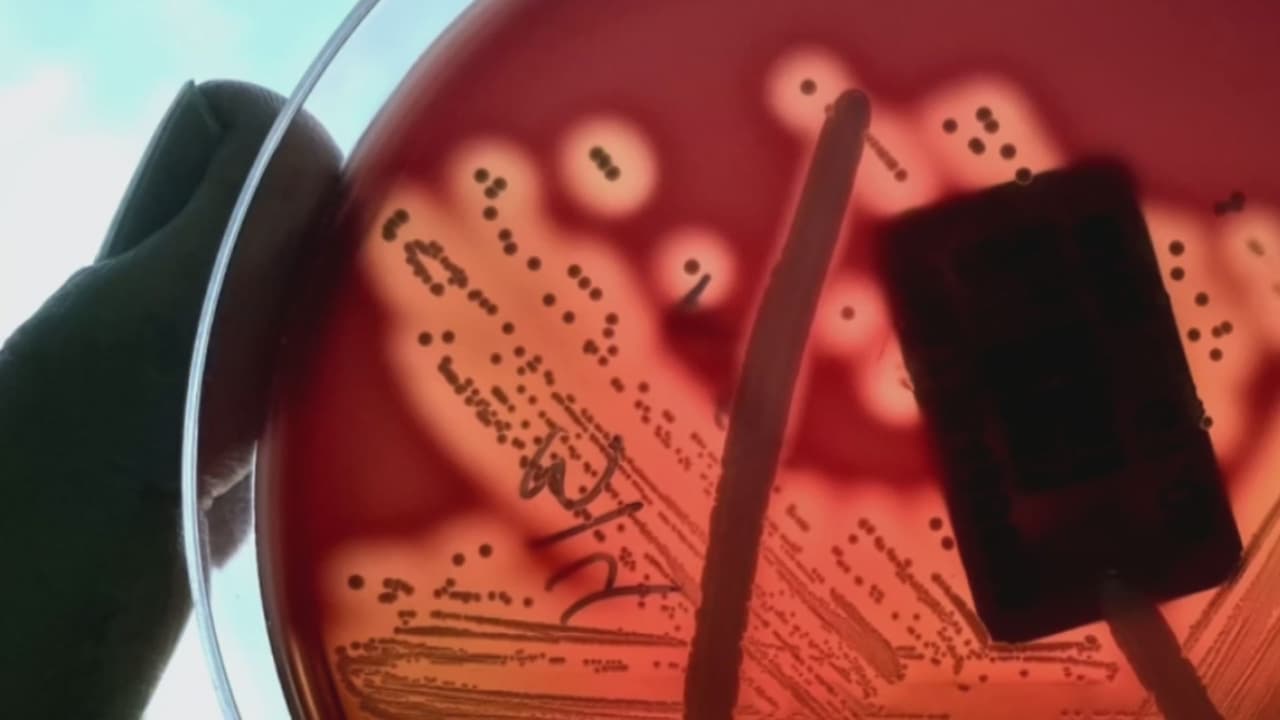

Un paciente del Hospital de Niños Prisma Health, en la ciudad de Columbia, en Carolina del Sur, falleció este martes por una meningoencefalitis causada por una infección de la llamada 'ameba comecerebros', informó la institución médica.
Muere una persona por una infección de la "ameba comecerebros" en Carolina del Sur
Un paciente del Hospital de Niños Prisma Health en Carolina del Sur, cuya identidad o edad no fue revelada, falleció tras una infección causada por la ameba Naegleria flowleri, conocida comúnmente como la 'ameba comecerebros'. Es el primer caso reportado en el estado desde 2016.
La víctima, de la que no se suministraron datos personales o edad, se cree que estuvo expuesta a la extraña pero mortal ameba en el lago Murray, de acuerdo con el Departamento de Salud del estado.
"Esta ameba infecta el cerebro y lo inflama. La mayoría de los casos ocurridos en Estados Unidos son mortales", afirmó la doctora Anna-Kathryn Burch, reseñada por WLTX News 19.
Las autoridades sanitarias del estado informaron que este es el primer caso en Carolina del Sur desde 2016. A nivel nacional, solo se han reportado 167 casos desde 1962.
El Centro para el Control de Enfermedades (CDC, por sus siglas en inglés), explica que la meningoencefalitis por ameba es rara. Es causada por la Naegleria fowleri, un organismo viviente unicelular. Vive en aguas frescas tibias y en el suelo.
La Meningoencefalitis Amebiana Primaria (MAP), es una condición difícil de diagnosticar y aunque los médicos pueden intentar tratar la infección con distintas medicinas, "suele ser mortal", indica el CDC.
La muerte usualmente ocurre dentro de los cinco primeros días desde el inicio de los síntomas, que pueden incluir dolor de cabeza, fiebre, náuseas y vómitos. La PAM progresa rápidamente.
La mayoría de las infecciones suceden luego de que las personas nada o sumergen sus cabezas bajo el agua en cuerpos acuáticos donde viva la ameba, que viaja a través de la nariz hacia el cerebro. Allí destruye el tejido cerebral, causando la inflamación del cerebro.
Los CDC subrayan que la infección no se propaga bebiendo agua contaminada ni de una persona enferma a otra sana.
En Estados Unidos, la mayoría de las infecciones están relacionadas con el nado en los estados del sur, aunque se ha observado una expansión en la presencia de la ameba hacia el norte a medida que el clima se calienta.
Vea también: